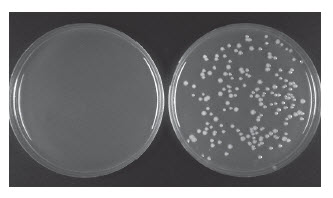
PCR 克隆试剂盒（不含感受态细胞） |

上海金畔生物科技有限公司代理New England Biolabs(NEB)酶试剂全线产品,欢迎访问官网了解更多产品信息和订购。
产品信息
- 经过升级,支持使用 SP6 和 T7 启动子进行体外转录
- 从含氨苄青霉素抗性的基因中去除 BsaI 位点(便于 Golden Gate 克隆)
- 添加了更多限制性酶切位点,包括四个 8 碱基切割酶
PCR 克隆试剂盒提供优化的克隆预混液(其中配有专有的连接增强剂)和线性载体。该线性载体利用独特的机制抑制背景菌落生长,使背景值降为最低。本试剂盒能简单、快速克隆各种 PCR 产物,包括具有校读功能的聚合酶产生的平末端扩增子(如:Q5®)和无校对功能的聚合酶产生的单碱基突出末端扩增子(如 Taq 或 Taq 预混液:OneTaq®、LongAmp® Taq)。克隆预混液中包含有末端修复成份,可在连接反应步骤前进行末端平齐化,因此,无论扩增子是何种末端都能完成有效连接。此外,使用本试剂盒,PCR 产物无需纯化,PCR 引物也无需经过 5´-磷酸基团修饰。
具有极强的灵活性:无论有没有 5´ 磷酸、是否进行纯化,任何 DNA 聚合酶制备的扩增子都能进行克隆!

用黑色字表示。其它用于亚克隆的酶切位点用红色字表示。底部的扩展框
标明了用于 PCR 或测序分析的引物位置,亚克隆或体外转录线性化的酶切位点,
及毒性小基因内插入片段的位置。
- 产品类别:
- DNA Assembly, Cloning and Mutagenesis Kits Products
-
试剂盒组成
本产品提供以下试剂或组分:
NEB # 名称 组分货号 储存温度 数量 浓度 -
E1203S -20 Linearized pMiniT™ 2.0 Vector N0312AVIAL -20 1 x 0.02 ml 25 µg/ml Amplicon Cloning Control N0555AVIAL -20 1 x 0.01 ml 15 µg/ml Cloning Analysis Reverse Primer S1513AVIAL -20 1 x 0.035 ml 100 µM Cloning Analysis Forward Primer S1512AVIAL -20 1 x 0.035 ml 100 µM Cloning Mix 1 M1015AVIAL -20 1 x 0.08 ml 2.5 X Cloning Mix 2 M1016AVIAL -20 1 x 0.02 ml 10 X
-
-
优势和特性
Features
- 含 SP6 和 T7 启动子,便于体外转录
- 从含氨苄青霉素抗性的基因中去除 BsaI 位点(便于 Golden Gate 克隆)
- 可以轻松克隆所有类型的 PCR 产物,包括平末端和 TA 末端
- 克隆速度快,连接仅需 5 分钟
- 筛选简单,几乎没有克隆背景,不需要蓝白斑筛选
- 无需纯化步骤,节约时间
- 两侧的限制性内切酶酶切位点方便亚克隆,包含两种单酶切选择
- 提供分析引物,便于进行下游菌落 PCR 筛选或测序
- 试剂盒包含 1 kb 对照扩增子和线性载体及一次用量的 E. coli 感受态细胞
- 比其它商业化产品保质期长(12 个月)
-
相关产品
相关产品
- Quick-Load® 紫色 1 Kb Plus DNA Ladder
- LongAmp® Taq 2X 预混液
- OneTaq® 2X 预混液(提供标准缓冲液)
- LongAmp® Taq DNA 聚合酶
- OneTaq® DNA 聚合酶
- dNTP 混合液
- NEB® 10-beta E. coli 感受态细胞(高效级)
- e2060-hiscribe-t7-arca-mrna-kit-with-tailing
- e2065-hiscribe-t7-arca-mrna-kit
- e2050-hiscribe-t7-quick-high-yield-rna-synthesis-kit
- e2040-hiscribe-t7-high-yield-rna-synthesis-kit
- SP6 RNA 聚合酶
- m0251-t7-rna-polymerase
- rNTP 混合液
- 小鼠 RNase 抑制剂
- m0307-rnase-inhibitor-human-placenta
-
注意事项
- NEB PCR 克隆试剂盒包含的试剂足以进行 20 次 10 μl 的克隆反应。试剂盒还提供引物,便于进行下游菌落 PCR 筛选和/或测序。
-
参考文献
- Wang, Y. et al. (2004). Nucleic Acids Research. 32, 1197-1207.
- Heurgue-Hamard, V. et al. (2000). The EMBO Journal. 19, 2701-2709.
- Tenson, T. et al. (1999). Journal of Bacteriology. 181, 1617-1622.
操作说明、说明书 & 用法
-
操作说明
- Insert Screening Protocols for NEB PCR Cloning Kit
- Plating Protocol for NEB PCR Cloning Kit
- Ligation Protocol for NEB PCR Cloning Kit
- Transformation Protocol for NEB PCR Cloning Kit
- RNA Synthesis of Cloned Insert Transcripts
-
说明书
产品说明书包含产品使用的详细信息、产品配方和质控分析。- manualE1202_E1203
-
使用指南
- NEB PCR Cloning Kit (NEB #E1202/E1203) Tips
- Tips for the Monarch PCR & DNA Cleanup Kit
FAQs & 问题解决指南
-
FAQs
- How does the NEB® PCR Cloning Kit work?
- How can the cloning vector work with both blunt-ended amplicons and single-base overhang-containing amplicons?
- Do these polishing components present in the master mix affect my cloning efficiency if my insert already has blunt ends?
- Do my inserts have to possess 5´ phosphates?
- Can the cloning kit be used for inserts that are not necessarily PCR amplicons?
- Can the cloning kit be used with inserts containing 5´ or 3´ overhangs greater than the single-base overhang achieved by PCR with Taq DNA polymerase?
- Can I use the NEB PCR Cloning Kit featuring pMiniT 2.0 for Golden Gate Assembly?
- Does the PCR product need to be purified?
- Can I use a different competent E. coli strain than the provided NEB 10-beta strain?
- How can I maximize the number of transformants?
- Can I scale down the reactions to use less vector?
- Are there limits regarding the size of inserts that can be cloned?
- Are the NEB 10-beta Competent E. coli (Cloning Efficiency) provided in the kit the same cells as NEB 10-beta Competent E. coli (High Efficiency)?
- How can I determine if my NEB 10-beta cells are competent?
- Can Cloning Mix 1 and Cloning Mix 2 be mixed together before adding them to the ligation reaction?
- Where are the +1 transcription positions for the SP6 and T7 promoters for in vitro transcription and translation located?
- What is the difference between the original pMiniT and the pMiniT 2.0 linearized vector backbone now provided in the kit?